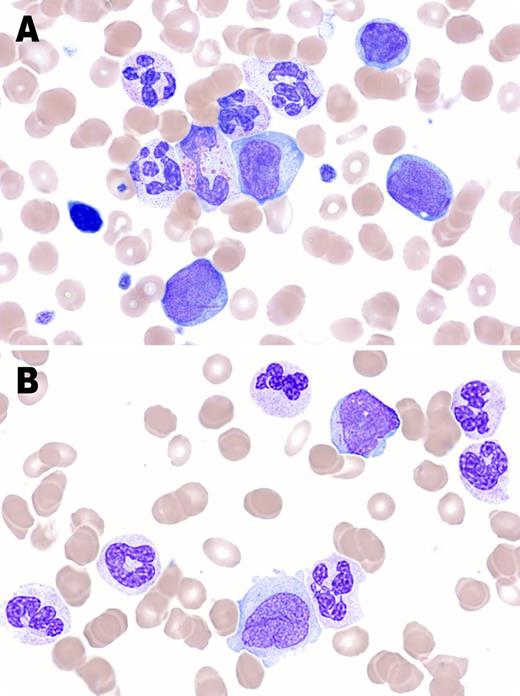

A 69-year-old man presented with anemia (hemoglobin, 77 g/L), thrombocytopenia (platelets, 84 × 109/L), and leukocytosis (white blood cell count, 31 × 109/L) including monocytosis (2.61 × 109/L). Blood film showed a leukoerythroblastic picture with nucleated red cells and blasts. Neutrophils had dysplastic features such as hyposegmented and hypersegmented nuclei, rare circular nuclei, and hypogranulation. Blasts, including myeloblasts, monoblasts, and promonocytes, comprised 8% of leukocytes. Some blasts contained Auer rods (panel A). Marrow aspiration demonstrated a hypercellular marrow with 13% blasts, including monoblasts and promonocytes which have open lacey chromatin and prominent nucleoli like monoblasts but with indented/folded nuclei (Br J Haematol. 2014;165(3):273-286), trilineage dysplasia, and Auer rods (panel B). Flow immunophenotyping showed most blasts were CD34-negative, including myeloid and monocytic subsets. Cytochemistry was not performed. Cytogenetic analysis showed a normal karyotype. These findings were consistent with chronic myelomonocytic leukemia type 2 (CMML-2) as per the World Health Organization 2008 diagnostic criteria. Presence of Auer rods fulfilled criteria for CMML-2, irrespective of the blast count.
Auer rods are a feature of some acute myeloid leukemias, but may be seen in refractory anemia with excess blasts type 2 and rarely in CMML-2 as demonstrated here. Presence of Auer rods indicates aggressive disease with risk of transformation into acute leukemia.
A 69-year-old man presented with anemia (hemoglobin, 77 g/L), thrombocytopenia (platelets, 84 × 109/L), and leukocytosis (white blood cell count, 31 × 109/L) including monocytosis (2.61 × 109/L). Blood film showed a leukoerythroblastic picture with nucleated red cells and blasts. Neutrophils had dysplastic features such as hyposegmented and hypersegmented nuclei, rare circular nuclei, and hypogranulation. Blasts, including myeloblasts, monoblasts, and promonocytes, comprised 8% of leukocytes. Some blasts contained Auer rods (panel A). Marrow aspiration demonstrated a hypercellular marrow with 13% blasts, including monoblasts and promonocytes which have open lacey chromatin and prominent nucleoli like monoblasts but with indented/folded nuclei (Br J Haematol. 2014;165(3):273-286), trilineage dysplasia, and Auer rods (panel B). Flow immunophenotyping showed most blasts were CD34-negative, including myeloid and monocytic subsets. Cytochemistry was not performed. Cytogenetic analysis showed a normal karyotype. These findings were consistent with chronic myelomonocytic leukemia type 2 (CMML-2) as per the World Health Organization 2008 diagnostic criteria. Presence of Auer rods fulfilled criteria for CMML-2, irrespective of the blast count.
Auer rods are a feature of some acute myeloid leukemias, but may be seen in refractory anemia with excess blasts type 2 and rarely in CMML-2 as demonstrated here. Presence of Auer rods indicates aggressive disease with risk of transformation into acute leukemia.
For additional images, visit the ASH IMAGE BANK, a reference and teaching tool that is continually updated with new atlas and case study images. For more information visit http://imagebank.hematology.org.